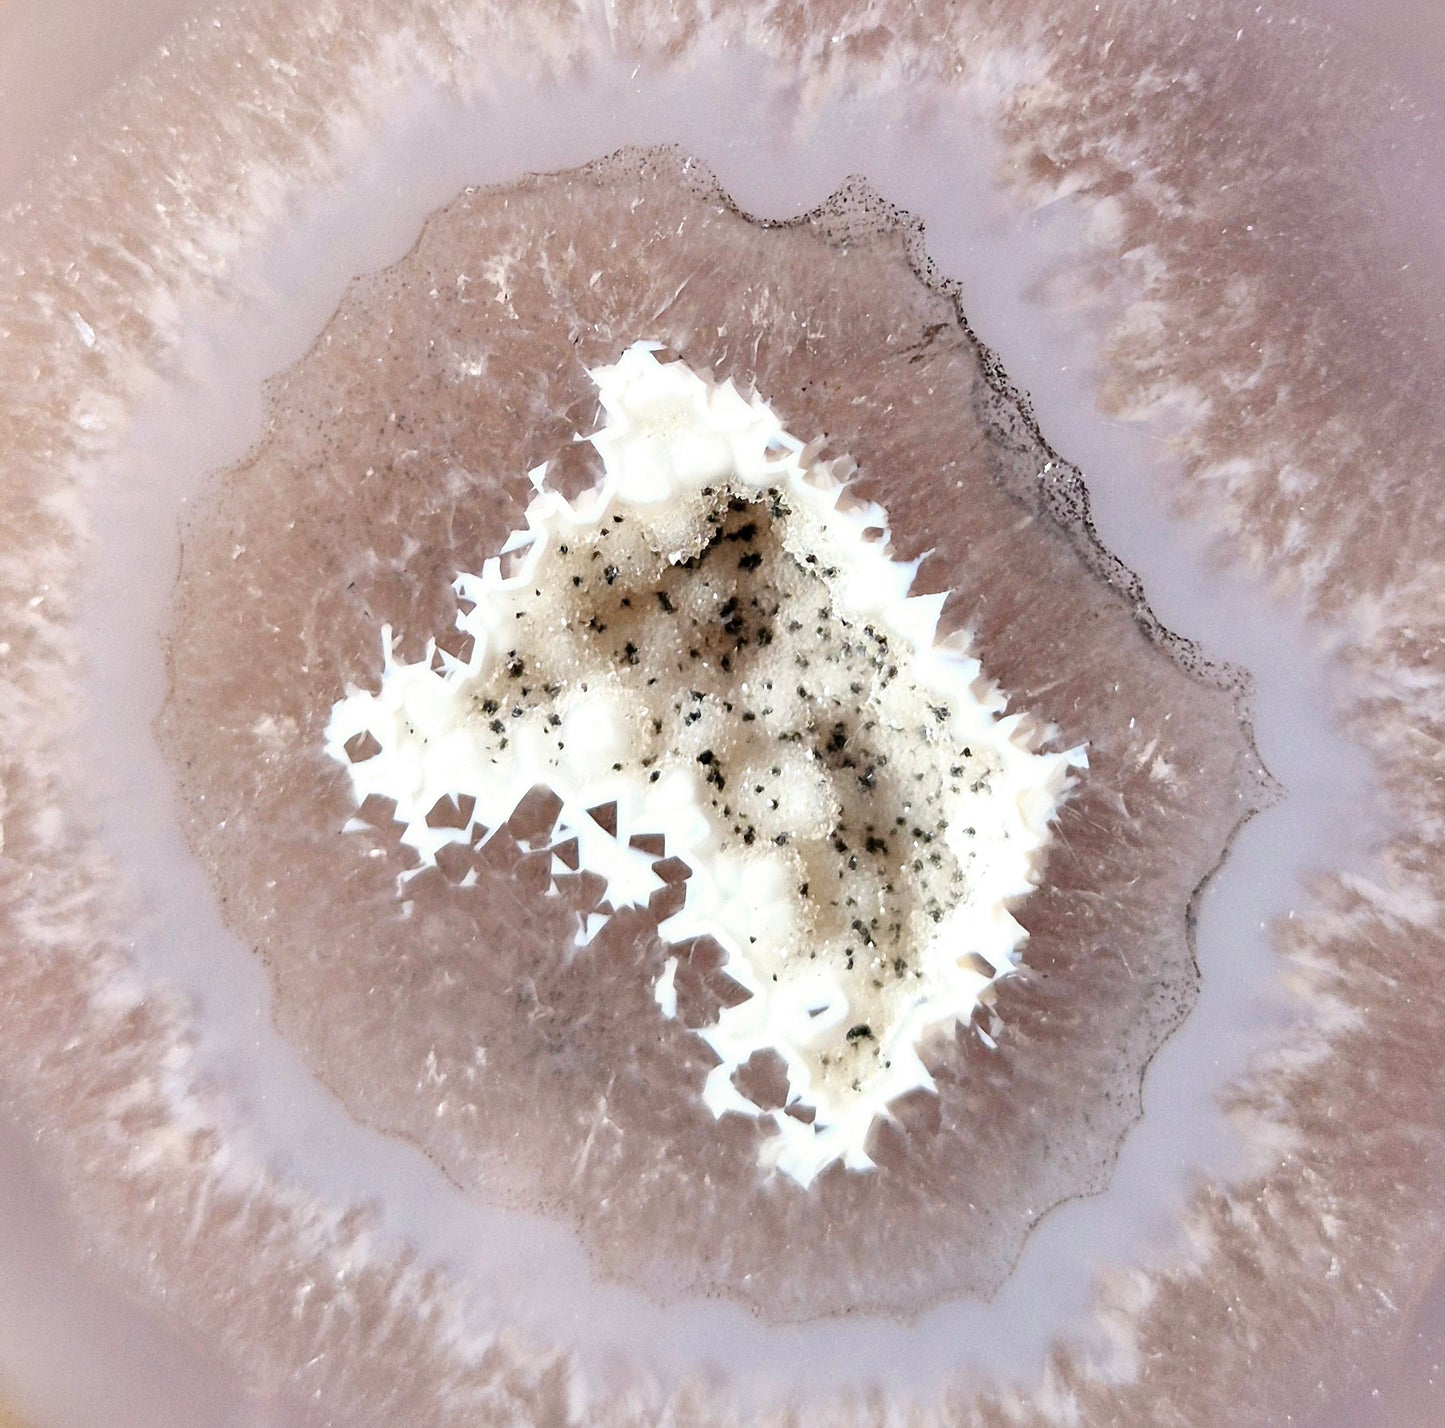

1
/
van
4
Unieke Druzy Agaat Half-Geode op Metalen Standaard 4
Unieke Druzy Agaat Half-Geode op Metalen Standaard 4
Normale prijs
€79,00 EUR
Normale prijs
Aanbiedingsprijs
€79,00 EUR
Eenheidsprijs
/
per
Belastingen inbegrepen.
Unieke Druzy Agaat Half-Geode op Metalen Standaard 4
Voeg een vleugje natuurlijke elegantie toe aan je interieur met deze one-of-a-kind Druzy Agaat half-geode, zorgvuldig gepresenteerd op een stevige metalen standaard. Deze unieke creatie combineert de natuurlijke schoonheid van agaat met een moderne, stijlvolle presentatie. De schitterende druzy-kristallen reflecteren het licht prachtig en creëren een betoverend schouwspel dat direct de aandacht trekt.
Belangrijkste kenmerken:
- Uniek: Elk stuk is volledig uniek in vorm, kleur en kristalstructuur.
- Ontwerp: Half-geode met glinsterende druzy-kristallen, gepresenteerd op een minimalistische metalen standaard.
- Energie: Agaat staat bekend om zijn kalmerende en aardende energie, ideaal voor het creëren van een rustgevende sfeer in huis.
- Toepassing: Perfect als decoratief statement piece in de woonkamer, slaapkamer of werkruimte.
- Afmetingen: Geschikt voor tafels, planken of vitrines; afmetingen kunnen variëren door de unieke natuur van elk stuk.
Gebruikstip: Plaats de geode op een plek met voldoende lichtinval om het glinsteren van de druzy-kristallen optimaal tot zijn recht te laten komen.
Product features
Product features
Materials and care
Materials and care
Merchandising tips
Merchandising tips
Share